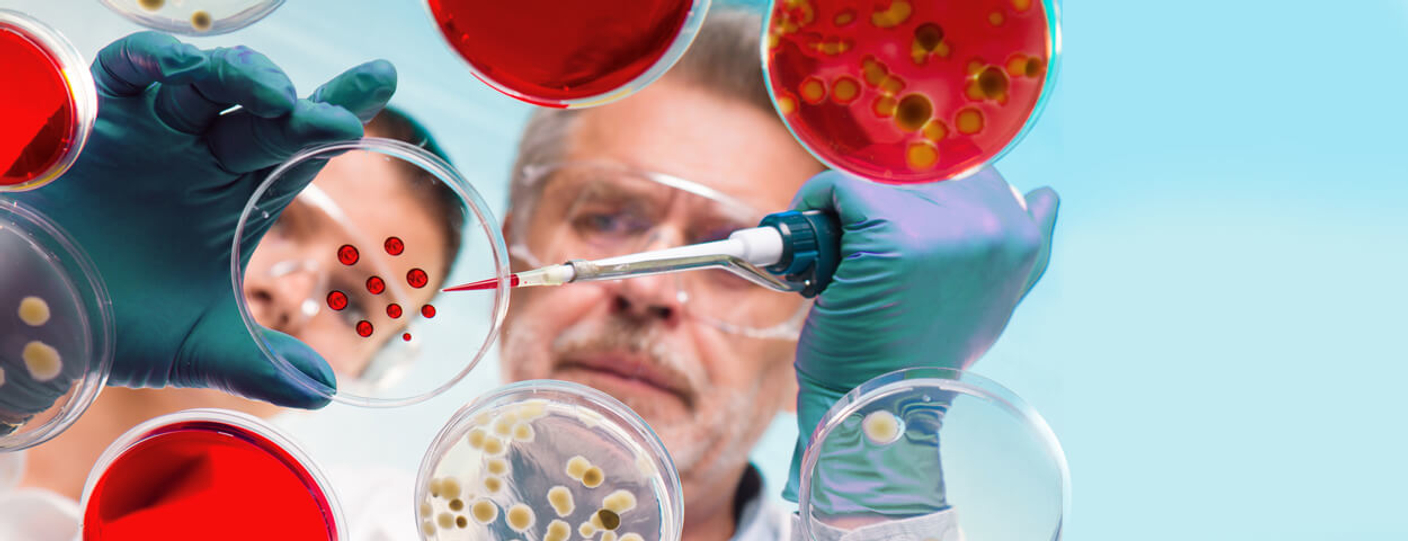

Старейшей медицинской специальностью считают лечение ран. И одной из главных задач в ранозаживлении является борьба с инфекционными осложнениями.
Инфицированные (гнойные) раны - это повреждения живых тканей, в которых из-за ослабления защитных сил организма развивается инфекционно-воспалительный процесс. Симптомы воспаления в ране обычно достаточно заметные - покраснение, отечность, боль, появление неприятного запаха и гнойного содержимого.
Присоединение бактериальной инфекции делает невозможным заживление раны и ухудшает общее состояние пациента.
Причины возникновения гнойных ран:
- Условия получения ран (например, травмы во время садово-огородных работ чаще осложняются инфекцией, чем хирургические раны).
- Несоблюдение правил асептики при обработке раны, которые влекут за собой присоединение вторичной инфекции.
- Снижение местного или общего иммунитета, приводящее к активном развитию в ране условно-патогенных микроорганизмов.
- Состояние здоровья, благоприятствующее развитию патологических бактерий (например, сахарный диабет, онкологические заболевания, изменение трофики тканей).


Для предотвращения и лечения раневой инфекции с древнейших времен придавалось большое значение очищению раны от всех внешних загрязнений, удалению инородных тел. Гиппократ призывал использовать для промывания ран только кипяченую воду и чистые полотняные бинты.
Только в середине XIX века были сформулированы основные правила асептики и антисептики.
Асептика - ряд мероприятий, направленных на предотвращение попадания болезнетворных микроорганизмов в рану.
Антисептика - борьба с уже попавшей в рану инфекцией.
Традиционные средства для антисептической обработки ран
Первые препараты для борьбы с инфекцией часто были токсичны и действовали по принципу “из пушки по воробьям”. В XIX веке хирурги использовали хлорную известь, спирт и фенол (карболовую кислоту), сульфат цинка и т.д.
В дальнейшем были найдены более безопасные решения. И в больничных условиях, и дома раны промывали перекисью водорода 3%, фурацилином и 0,5% раствором перманганата калия (марганцовкой), хлоргексидином. Края раны обрабатывали спиртовым раствором зелёнки или йода.
Хорошая противомикробная активность - основной плюс этих препаратов. Но, наряду с этим, существует и ряд минусов:
- бактерицидное действие длится непродолжительное время;
- спиртовые растворы и перекись обжигают раневую поверхность, что приводит к отмиранию клеток и образованию струпа (корочки), под которым заживление проходит сложнее;
- такие яркие средства, как зелёнка, йод или фукорцин, окрашивают кожу вокруг раны, чем маскируют возможные симптомы воспаления.
Этих недостатков лишены современные средства для противоинфекционной обработки ран, кожи и слизистых.
Современные средства для борьбы с раневой инфекцией
В ассортименте магазина КАМА представлены новейшие антисептические препараты:
- растворы для промывания ран;
- гидрогели с бактерицидным и ранозаживляющим эффектом;
- гели с бактериофагами для восстановления нормальной микрофлоры и борьбы с болезнетворными бактериями на коже и слизистых;
- ранозаживляющие повязки с хлоргексидином, повидон-йодом и с ионами серебра.
Растворы-антисептики для промывания ран
Спрей Октенисепт - высокоэффективный бесспиртовой антисептик для обработки ран, кожи и слизистых на основе октенидина гидрохлорида. Бактерицидное действие Октенисепта начинается в течение первой же минуты с момента нанесения и продолжается минимум час. В отличие от спиртовых антисептиков, которые перестают действовать, как только спирт испаряется.
Раствор для промывания ран Пронтосан содержит полигексанид - поверхностно-активное вещество, которое разрушает биопленки, уничтожая большинство возбудителей инфекции. Биопленки - это конгломераты микроорганизмов на поверхности ран, которые и являются причиной развития воспалительного процесса. Пронтосан не только уничтожает бактерии, но и защищает рану от вторичного инфицирования в течение длительного времени. Рекомендуется применять вместе с гидрогелем Пронтосан.

Гидрогели с бактерицидным и ранозаживляющим эффектом
Гель Пронтосан содержит полигексанид и ундециленамидопропил бетаин - вещества с высокой противомикробной активностью. Благодаря консистенции он долгое время остается в ране, защищая её от инфекции, увлажняя и способствуя заживлению. Прозрачный прохладный гидрогель не пересушивает и не раздражает раневую поверхность. Может применяться совместно с большинством современных повязок (исключение - бактерицидные повязки).
ЭверсЛайф Гель - ранозаживляющее средство с бактерицидным и обезболивающим эффектом. В его составе эффективный болеутоляющий компонент - лидокаин. Бактерицидный эффект обеспечивает хлоргексидин - антисептик широкого спектра. А декспантенол стимулирует регенерацию поврежденных тканей.
Гели с бактериофагами для кожи, слизистых и ран
Бактериофаги - это вирусы, входящие в состав естественной микрофлоры человека. Они избирательно уничтожают болезнетворные бактерии и поддерживают полезные. При местном применении бактериофаги помогают бороться с инфекцией. При этом бактериофаги, в отличие от антибиотиков, не имеют побочных эффектов, таких как дисбактериоз или микозы, и не формируют у бактерий устойчивости к лечению.
Фагодерм - гель с бактериофагами для профилактики и лечения кожных инфекций и антисептической обработки ран.
Фагодент - гель с бактериофагами для ухода за полостью рта, профилактики и лечения воспалительных заболеваний зубов и дёсен.
Фагогин - гель с бактериофагами для интимной гигиены и санации органов мочеполовой системы.
Отофаг - гель с бактериофагами для профилактики и лечения инфекций лор-органов.

Ранозаживляющие повязки с серебром, повидон-йодом и хлоргексидином
После того, как рану промыли и обработали антисептиком, необходимо создать ей условия для заживления. Для этого принято использовать специальные раневые повязки. Если в рану попала инфекция и начался воспалительный процесс, то на помощь приходят именно бактерицидные повязки.
Повязки с серебром эффективно борются с бактериями, при этом ионы серебра не проникают в организм пациента, а действуют лишь на поверхности раны. Такие раневые покрытия могут оставаться на ране несколько дней (частоту перевязок назначает лечащий врач).
Повидон-йод - это препарат на основе йода и поливинилпирролидона, не содержащий спирта. Повязки с повидон-йодом обеспечивают продолжительное лечебное действие и подходят для длительно незаживающих ран, таких как трофические и диабетические язвы и пролежни.
Повязки с хлоргексидином подходят для лечения гнойных ран людям с непереносимостью йода и/или препаратов серебра. Повязка ГексоТекс имеет сетчатую структуру и не прилипает к ране, что делает перевязки безболезненными и комфортными.
- Подбор средств для лечения ран должен проводиться лечащим врачом индивидуально.
- Внимательно читайте инструкцию по применению ранозаживляющих средств.
- При появлении раздражения и симптомов аллергии немедленно прекратите использование средства и обратитесь к врачу.
На сайте kama-med.ru вы можете получить бесплатную консультацию эксперта по подбору средств для ухода за ранами.
Будьте здоровы!